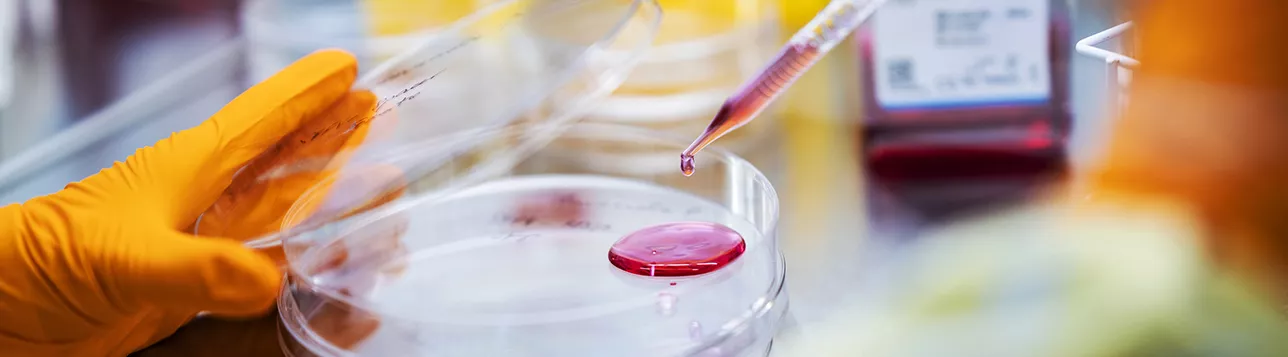

Stem cell research
We are advancing stem cell research, unlocking the potential of stem cells to develop improved treatments and cures for the patients of tomorrow.
A stem cell is a cell that can both replicate itself and develop into various specialised cells in the body, such as blood cells, nerve cells or insulin-producing cells. This combination of unique abilities makes stem cells an invaluable resource when patients need to have damaged tissues and organs replaced.
Cutting-edge research
Through diverse and pioneering stem cell research, our researchers are contributing to the development of innovative treatments for neurological conditions, blood diseases, cancer, diabetes and more.
Researchers are studying several topics, including:
- Biotechnology – developing advanced technologies to enable new methods in regenerative medicine. For example using stem cells to grow tissues and organs in the laboratory
- Haematology – studying blood stem cells to help advance the development of new treatments for blood diseases
- Immunology – harnessing stem cells to develop innovative treatments for cancer and autoimmune diseases
- Neuroscience – exploring the use of stem cells for the treatment of neurological disorders such as Parkinson's disease and stroke.
Prominent research environment
Our research is conducted in modern high-tech facilities at the Lund Stem Cell Center, which enables advanced basic, applied and clinical research. With its proximity to Skåne University Hospital and the Öresund Region’s life science cluster, the center has become an international hub for stem cell research.
Lund Stem Cell Center currently brings together more than 45 different research teams, over 300 researchers, doctors, students and other staff. They are all working towards a common goal: to investigate how stem cells can be used to understand, treat and alleviate a wide range of diseases.
Application areas
Our researchers are working closely with organisations inside and outside academia to develop new solutions in areas such as:
Our researchers contribute to the development of Advanced Therapy Medicinal Products (ATMPs).
ATMPs distinguish themselves from conventional drugs in that their active substance is produced in or derived from, living cells, genes, tissues or other biological materials.
These types of therapies include cell and gene therapies, which are intended to cure, treat or alleviate various forms of cancer, Parkinson's disease, diabetes and other diseases.
An example of an advanced therapy medicinal product is STEM-PD, which uses stem cells to treat Parkinson's disease. The Swedish Medical Products Agency approved the treatment in 2022 for a clinical trial on patients.
We are all different, and this affects how we respond to medicines and the potential side effects we may experience.
Currently, our researchers are using different types of stem cells, including induced pluripotent stem cells (iPSCs), alongside advanced technology to develop patient-specific disease models in the laboratory, called mini-organs or organoids.
These models have multiple usage areas, for example, they can be used to test drugs and to develop treatments tailored to the specific needs of individual patients.
Our researchers are developing techniques to create artificial organs and tissues through 3D printing technology that uses biological ink made from cells and other complementary materials.
This innovative approach could lead to new treatment options for patients with organ failure or tissue damage caused by cancer and lung diseases.
Research environments
The following links are to other websites.
Strategic research area
A significant part of the stem cell research at Lund University is conducted within StemTherapy – Stem cells and regenerative medicine, which is a strategic research area (SRA) in Sweden.
Within StemTherapy, Lund Stem Cell Center and Uppsala University work closely together.
Coordinator
Malin Parmar
Professor in Cellular Neuroscience
Mobile: +46(0)46 222 06 20
malin [dot] parmar [at] med [dot] lu [dot] se
Research coordinator
Claire McKay
Mobil: +46(0)70 216 7319
claire [dot] mckay [at] med [dot] lu [dot] se (claire[dot]mckay[at]med[dot]lu[dot]se)
Website
Research database
Related researchers, projects and publications.
Latest news in stem cell research

Why repetitive DNA matters for human brain evolution and disease

Two researchers receive ERC Proof of Concept grants
